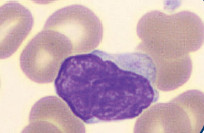

Apport de la cytométrie en flux dans le diagnostic et le suivi du syndrome de Sézary

Définition et épidémiologie
Le syndrome de Sézary (SS) est un variant agressif de lymphome T cutané primitif (CTCL), le mycosis fungoïde (MF). Il s’agit d’un lymphome rare (3% des CTCL) qui se distingue par son mauvais pronostic (25% de survie à 5 ans); la mortalité étant liée en grande majorité à des complications infectieuses.
Difficultés diagnostiques
Le SS est caractérisé sur le plan clinique par une érythrodermie exfoliative et des adénopathies périphériques, et sur le plan biologique par la prolifération d’un clone lymphocytaire T CD4+ mature, qui se localise dans le sang et la peau
Aspect clinique
La présentation clinique pose le problème du diagnostic différentiel des autres dermatoses inflammatoires érythro-dermiques, d’autant plus qu’un clone T peut y être également détecté.
Aspect biologique
Les cellules de Sézary (CS) circulantes sont recherchées sur frottis sanguin grâce à leurs caractéristiques cytologiques particulières (cellules de taille moyenne, au noyau irrégulier « cérébriforme »). Cependant ce critère peut être pris en défaut : l’identification reste observateur dépendant et l’aspect morphologique n’est pas spécifique des cellules malignes.
La cytologie sanguine doit être confirmée par la détection d’un clone lymphocytaire T en cytométrie en flux (CMF). Elle est basée sur l’absence des marqueurs pan-T comme le CD7 et/ou le CD26 mais la perte de ces marqueurs peut s’observer à l’état physiologique ou dans certaines dermatoses inflammatoires bénignes.
Les recommandations EORTC/ISCL de 2007, 2011 et 2018 ont émis des valeurs seuils relatives et absolues permettant de classer les MF/SS selon des critères cytométriques (B0-B1-B2).
LE DIAGNOSTIC DU SYDROME DE SÉZARY EST COMPLEXE, SOURCE D’ERRANCE DIAGNOSTIQUE ET THÉRAPEUTIQUE.
APPORT DU CD158K (KIR3DL2)
Clé de voûte du diagnostic de syndrome de Sézary
Depuis 2019, de nouveaux critères diagnostiques et de stadification ont été proposés, incluant le récepteur CD158k/KIR3DL2, décrit comme marqueur spécifique des CS. Ce récepteur appartient à la famille des « Killer-cell Immunoglobulin-like Receptors » (KIRs).
L’étude de Roelens et al a montré que, devant un stade T4 (érythrodermie ≥ 80% de la surface corporelle totale selon classification ISCL/EORTC), le seuil de 200/μL et/ou de 10% de CS CD158k+ permet d’établir un diagnostic initial de SS avec une sensibilité de 89% et une spécificité de 96%, alors que la sensibilité des CD4+CD7- n’est que de 69% (cf graphique ci-dessous).
DIAGNOSTIC FINAL
Détection d’un clone T identique dans le sang et la biopsie de peau en biologie moléculaire
De plus, ces seuils sont particulièrement informatifs lorsque la numération des TCD4+ est inférieure à 1600/μL, et permettent ainsi un diagnostic plus précoce.
Les résultats indiquent par ailleurs que chez plus de la moitié des patients, une fraction ≥ 30% des TCD4+ bénins (non Sézary) n’exprime pas le CD26. Ceci est problématique lors du suivi de ces patients, la numération des TCD4+CD26- pouvant sous-estimer la réponse sanguine aux traitements.
CD158K / KIR3DL2
Diagnositc précoce et suivi de la réponse au traitement
Les laboratoires OuiLab mettent en œuvre ce panel multiparamétrique pour la recherche et le suivi des CS. Pour une interprétation optimale des résultats, il est important d’indiquer le contexte de prescription.
QUE PRESCRIRE?
«Immunophénotypage lymphocytaire pour recherche de cellules de Sézary (préciser le contexte : mycosis fungoïde /syndrome de Sézary / suivi thérapeutique /érythrodermie généralisée…)»
Bibliographie
Roelens M, et al. Revisiting the initial diagnosis and blood staging of mycosis fungoides and Sezary syndrome with the KIR3DL2 marker. Br J Dermatol. 2019
Olsen E, et al. Iscl/Eortc. Revisions to the staging and classification of mycosis fungoides and Sezary syndrome: a proposal of the International Society for Cutaneous Lymphomas (ISCL) and the cutaneous lymphoma task force of the European Organization of Research and Treatment of Cancer (EORTC). Blood. 2007;110(6):1713-1722.
Callet J, Latger-Cannard V et al. Apport du panel multiparamétrique CD3 CD4 CD8 CD7 CD26 CD158k dans la détection et le suivi par cytométrie en flux des cellules de Sézary. Ann Biol Clin 2021; 79(3):233-40,
Document à télécharger